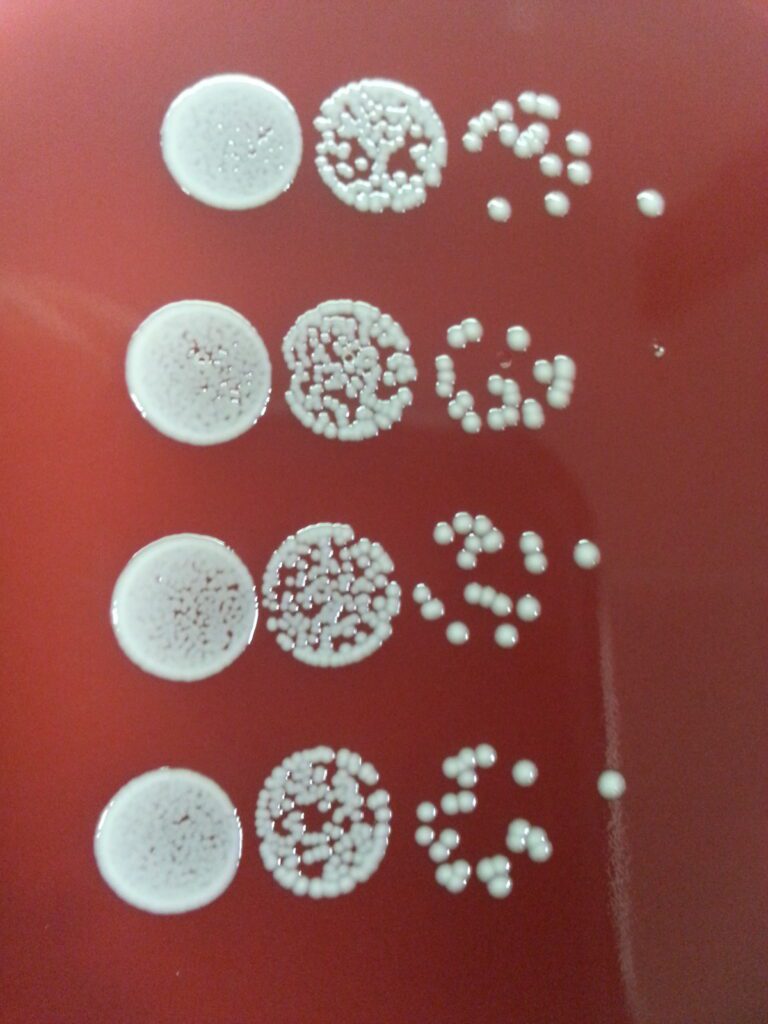

Leistungs- und Sicherheitsprüfungen
MDC unterstützt mit mikrobiologischer Expertise bei risikobasierten Test-Designs, sorgt für einen reibungslosen Prüfprozess und unterstützt professionell bei der Bewertung und Dokumentation der Ergebnisse.
in vitro Wirksamkeitsprüfungen
Je nach Zweckbestimmung (z.B. Desinfektion von Flächen, Händen oder Instrumenten, Vordesinfektion oder Abschlussdesinfektion) muss die Wirksamkeit gegenüber verschiedenen Keimen anhand standardisierter Norm-Prüfmethoden nachgewiesen werden.
MDC hilft, zeit- und kosteneffizient zu prüfen. Es wird ein Prüfplan entsprechend der Wirkstofftoleranz der Keime erstellt, MDC organisiert die Prüfungsprozesse, prüft und bewertet die Laborergebnisse.

Wirksamkeit antimikrobieller Materialien
Gegenwärtig ist die Auswahl an Standard-Testmethoden für die Prüfung antimikrobieller Materialien begrenzt. MDC unterstützt Sie bei der Definition des Test-Setups und hinsichtlich Prüfmethode, Organisation, Bewertung und Dokumentation der Prüfung.
Wirksamkeit gegenüber Biofilmen
In Biofilmen können Bakterien bis zu 1000 Mal toleranter gegenüber Antibiotika und Bioziden sein. Gegenwärtig gibt es noch keine standardisierte Norm-Prüfmethode zur Wirksamkeitsprüfung gegenüber Biofilmen. MDC hilft bei der Auswahl der Prüfmethodik und Organisation der Prüfung.


Anwendungsnahe Wirksamkeitsprüfung - Typprüfungen
MDC hilft bei der Prüfung von von Abschlussdesinfektionsmitteln für die maschinelle Aufbereitung flexibler Endoskope wie z.B. Typprüfung der Wirksamkeit von maschinellen High Level Desinfektionsmitteln unter Anwendungsbedingungen in Endoskop-Reinigungs- und Desinfektionsgeräten.
Biokompatibilität
MDC hilft bei der Erstellung eines risikobasierten Prüfkonzepts nach ISO 10993 bei der biologischen Bewertung von Medizinprodukten, der Prüfung auf Leachables and Extractables, Literatursuche und bei der toxikologisch-chemischen Bewertung von Rückständen.





